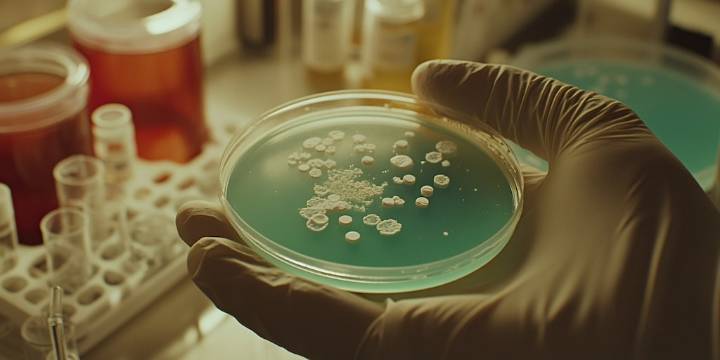

El descubrimiento de Tersicoccus phoenicis en ambientes ultracontrolados de la NASA desafía las principales estrategias de desinfección y plantea dudas sobre la protección planetaria.
Científicos de la Universidad de Houston identificaron a este microorganismo en salas limpias de ensamblaje, donde los protocolos de limpieza y monitoreo alcanzan su máximo nivel, pero no consiguieron eliminarlo totalmente. Gracias a su habilidad para entrar en un estado de latencia , la bacteria sobrevive incluso en condiciones extremas y logra evitar la detección durante largos períodos. El estudio fue publicado en la revista Microbiology Spectrum
Un huésped inesperado en las salas limpias
La Tersicoccus phoenicis fue identificada hace más de 10 años en dos de los lugares con mayor con

 Infobae
Infobae
La Nación Sociedad
La Nación Sociedad ESPN Cricket Headlines
ESPN Cricket Headlines America News
America News The Conversation
The Conversation Raw Story
Raw Story Essentiallysports College Sports
Essentiallysports College Sports Tom's Guide
Tom's Guide New York Post
New York Post NHL Arizona Coyotes
NHL Arizona Coyotes